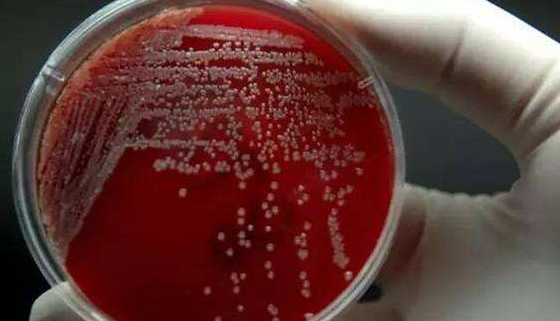
什么是食肉菌
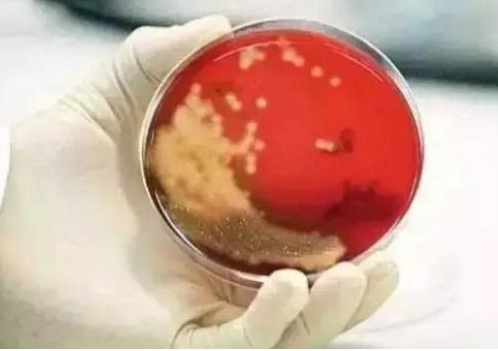
什么是食肉菌

什么是食肉菌
的有关信息介绍如下:体臭太浓让飞机迫降,戏剧性的一幕走向悲剧,关键词是“食肉菌”。但“食肉菌”却不是新发现的凶猛细菌,也不是单一的病菌。
医生表示食肉菌是指会引起“坏死性筋膜炎”的一些混合病菌,是细菌的“组合作乱”,这些病菌感染皮下筋膜引起发炎,临床病程快速而严重,常表现为片状红肿、疼痛、麻木,皮下组织坏死导致高热、寒战、低血压等一系列症状,产生的毒素被人体吸收,又会进一步导致肝肾损伤,使得病情急转直下,常伴有全身中毒性休克。
虽然名叫“食肉菌”,但“食肉”只是一种形象的说法。食肉菌的感染临床表现为沿着皮肤下深深浅浅的筋膜扩散的感染,它会侵犯血管,在血管内形成血栓,从而导致皮下组织、皮肤和筋膜等的坏死,看起来就像“食肉”一样。



